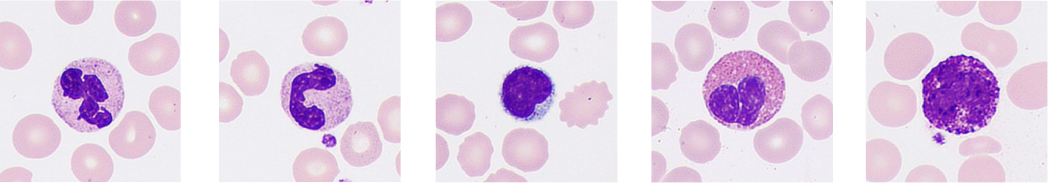

Conozca la verdad sobre la morfologรญa celular
Mindray 2021-12-23

Muchos laboratorios tienen problemas tales como procesos de anรกlisis prolongados y exรกmenes microscรณpicos menos eficientes, debido a la falta de expertos en morfologรญa celular y al uso de equipos inadecuados. Esto hace que sea difรญcil alcanzar una tasa general de reexamen del 30 %, un objetivo recomendado por el grupo de consenso internacional para la revisiรณn de hematologรญa. Ademรกs, las habilidades del personal del laboratorio son variadas, lo que ocasiona inconsistencias en los estรกndares y resultados de laboratorio.
El analizador de morfologรญa celular automรกtico MC-80 de Mindray estรก dise?ado para proporcionar "mรกs claridad, mรกs inteligencia y mรกs productividad" al anรกlisis de la morfologรญa celular, y cuenta con herramientas inteligentes para ayudar a descubrir la verdad sobre las cรฉlulas.
Debido a su compromiso por mejorar la eficiencia y la precisiรณn de los laboratorios, Mindray colabora con expertos y acadรฉmicos en hospitales de todo el mundo desde 2014. Sobre la base de una intensa investigaciรณn, Mindray ha desarrollado soluciones innovadoras en imรกgenes de cรฉlulas, como la tecnologรญa de fusiรณn multicapa, el sistema antivibraciรณn hiperestable "Solid Rock", la tecnologรญa Fly-mode y muchas mรกs.
Mรกs claridad: mรกs detalles que superan las apariencias
Las cรฉlulas son las unidades bรกsicas de la vida, y la prueba de morfologรญa celular es una de las principales herramientas para detectar enfermedades malignas. Los patรณlogos estudian la estructura interna y los detalles de las cรฉlulas por diversas necesidades.
Actualmente, en la mayorรญa de los laboratorios, los expertos en morfologรญa observan las imรกgenes celulares de cada muestra de reexamen manualmente con un microscopio. Esto hace que sea un proceso prolongado cuando el volumen de pruebas es grande.
IPara aliviar eficazmente la carga de trabajo del anรกlisis manual con un microscopio, los analizadores de morfologรญa celular deben simular los detalles capturados por la microscopรญa manual con la mayor claridad posible. ?Cรณmo pueden lograr esto las imรกgenes planares de las cรฉlulas?
El MC-80 captura de manera innovadora 20 imรกgenes de cada cรฉlula a diferentes profundidades de campo.

La esencia de la tecnologรญa de fusiรณn de profundidad mรบltiple consiste en recrear el enfoque manual normalmente realizado por el mรฉdico superponiendo las partes claras de las 20 imรกgenes. En las imรกgenes de cรฉlulas del MC-80, se pueden observar con claridad las caracterรญsticas y los detalles internos de las cรฉlulas normales y anormales.

Por lo tanto, los mรฉdicos pueden obtener informaciรณn sobre las caracterรญsticas patolรณgicas de las cรฉlulas para una detecciรณn temprana mรกs precisa de los trastornos sanguรญneos y las enfermedades infecciosas; esto evita la detecciรณn errรณnea.
The essence of the multi-depth fusion technology is to recreate manual focusing normally performed by the doctor by superimposing the clear parts of the 20 images. In the cell imaging from the MC-80, the features and internal details of normal and abnormal cells can be clearly presented.
Therefore, doctors can gain insight into the pathological features of cells for more accurate early screening of blood disorders and infectious diseases, avoiding misdetection.
Mรกs inteligencia: una vista completa de las muestras

Entre la informaciรณn compleja, la informaciรณn desordenada no es vรกlida y crea una barrera entre los mรฉdicos y la verdad.
La recopilaciรณn de imรกgenes de cรฉlulas es solo el comienzo. Es por ello que es necesario clasificar cada cรฉlula correctamente para reflejar la visiรณn completa de la muestra. Cuando se realiza un anรกlisis manual, el mรฉdico suele registrar el proceso de clasificaciรณn uno por uno. Sin embargo, dado que los distintos tipos de cรฉlulas son similares, los mรฉdicos solo pueden clasificarlas en funciรณn de sus detalles. Con el tiempo ocurren errores que pueden afectar la precisiรณn y la eficiencia.
Por medio de la identificaciรณn confiable y la clasificaciรณn previa de los diferentes tipos de cรฉlulas, el MC-80 puede reflejar con precisiรณn la vista completa de la muestra. Esto ayuda a los mรฉdicos a comprender el estado del paciente.
El reconocimiento preciso se basa en la extracciรณn exacta de caracterรญsticas de las imรกgenes digitales de las cรฉlulas. Con la ayuda de expertos en morfologรญa y patologรญa en la etapa inicial, el equipo de Mindray extrae la informaciรณn sobre el color, la textura y las caracterรญsticas geomรฉtricas de las cรฉlulas en diferentes escalas. Al mejorar la tasa de reconocimiento de las cรฉlulas mediante la clasificaciรณn en cascada, los patรณlogos pueden confirmar con precisiรณn los tipos de cรฉlulas mediante la comparaciรณn dentro de categorรญas y subcategorรญas.
Mejora de la tasa de reconocimiento celular mediante la clasificaciรณn en cascada

El MC-80 puede ajustar inteligentemente el modo de anรกlisis antes y durante el proceso de acuerdo con la informaciรณn de la lรญnea de anรกlisis celular con el fin de mejorar la eficiencia del diagnรณstico.


Para los falsos recuentos de plaquetas disminuidas debido a la aglutinaciรณn, el MC-80, con su exclusivo FLY-MODE de alta velocidad, puede escanear el cuerpo, ambos lados y la cola del frotis en un minuto e identificar con precisiรณn la acumulaciรณn de plaquetas, lo que evita la confirmaciรณn manual y ahorra el tiempo que esta lleva.
Mรกs productividad: mejorar la eficiencia del anรกlisis morfolรณgico
Hasta ahora, con una iluminaciรณn estable, capturar una imagen clara requiere un tiempo de exposiciรณn prolongado y casi ningรบn movimiento de la cรกmara. Parece que la velocidad y la claridad no se pueden conseguir al mismo tiempo.
Lo mismo ocurre con el anรกlisis de la morfologรญa celular. Ademรกs de la claridad, la eficiencia tambiรฉn es importante para encontrar la verdad mรกs rรกpidamente. El anรกlisis manual tradicional toma de 5 a 8 minutos por cada muestra. En los grandes laboratorios, la enorme carga de trabajo requiere de personal especializado, lo que genera altos costos laborales.
El laboratorio debe revisar una gran cantidad de muestras.

Solo al completar la prueba mรกs rรกpidamente se puede divulgar aรบn mรกs el examen microscรณpico. El aumento de la eficiencia de las pruebas de morfologรญa celular es un objetivo importante en la bรบsqueda de la verdad.
El MC-80 captura constantemente imรกgenes de cรฉlulas a alta velocidad y procesa una muestra por minuto. A travรฉs del muestreo flexible de un solo portaobjetos, se pueden generar resultados rรกpidamente para casos urgentes.
En comparaciรณn con los analizadores de cรฉlulas tradicionales, el MC-80 tiene muchas caracterรญsticas innovadoras.

Cantidad total de imรกgenes tomadas por hora

El MC-80 estรก equipado con un sistema antivibraciรณn hiperestable SOLID ROCK integrado. Luego de repetidas verificaciones, el nuevo material aeroespacial puede proporcionar la rigidez requerida por el MC-80 durante el movimiento a alta velocidad. La estructura estable y el algoritmo de exposiciรณn avanzado de alta frecuencia pueden abordar la peque?a perturbaciรณn horizontal y vertical para garantizar un anรกlisis celular rรกpido, preciso y confiable.
En caso de problemas tรฉcnicos durante el examen, el MC-80 permite la validaciรณn remota desde mรบltiples terminales, lo que permite que la consulta estรฉ disponible de inmediato.
Revisiรณn y consulta remota desde mรบltiples ubicaciones

MC-80
Analizador de morfologรญa celular digital automatizado
Mรกs claridad, mรกs inteligencia, mรกs productividad.
El analizador de morfologรญa celular automatizado MC-80 de Mindray proporciona un anรกlisis morfolรณgico mรกs preciso y confiable gracias a su tecnologรญa lรญder en la industria en el campo. Al abordar los desafรญos clave del anรกlisis morfolรณgico, Mindray proporciona una soluciรณn integral de anรกlisis de hematologรญa automรกtico para potenciar la confianza, lo que brinda resultados precisos al mismo tiempo que satisface las demandas de eficiencia de laboratorios en todo el mundo.










